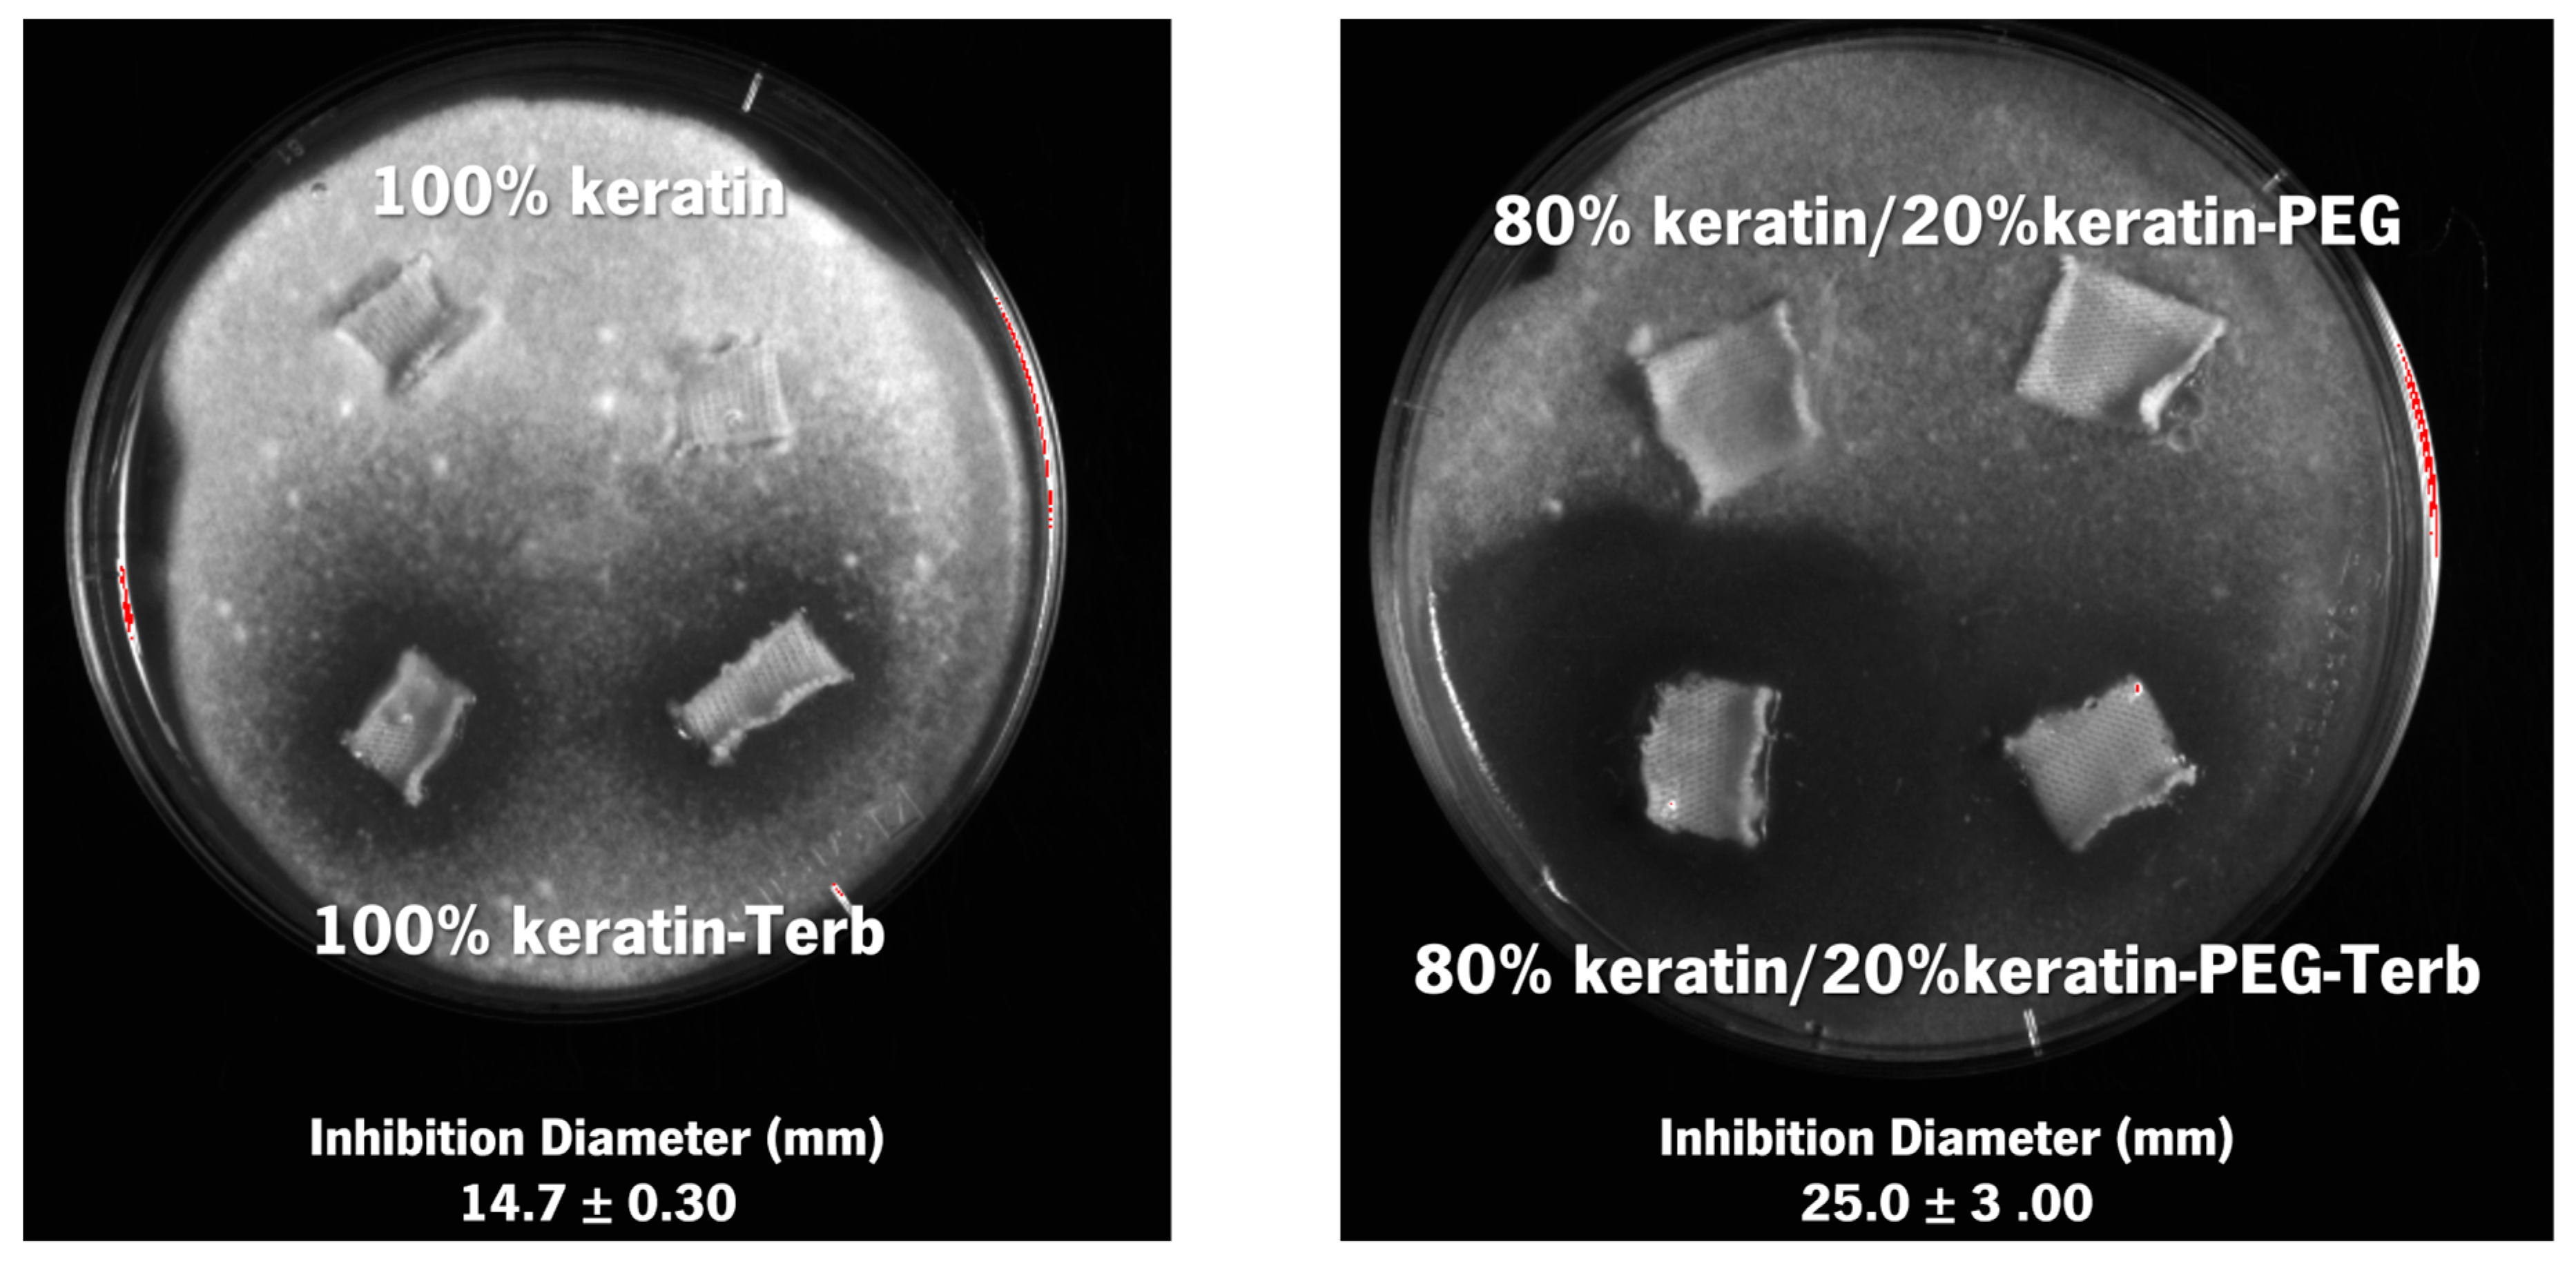
Ijms 23 13999 g009 Ijms 23 13999 g009

Therapeutic Textiles Functionalized with Keratin-Based Particles Encapsulating Terbinafine for the Treatment of Onychomycosis
Abstract
1. Introduction
2. Results and Discussion
2.1. Keratin PEGylation
2.2. Characterization of the Keratin-Based Particles
Characterization of the Functionalized Cotton Fabrics
2.3. Antimicrobial and Antifungal Activity
3. Materials and Methods
3.1. Keratin Extraction and Purification
3.2. Keratin PEGylation
3.3. Production of Keratin-Based Particles
Particles Formation
3.4. Particles Characterization
3.4.1. Formation Efficiency
3.4.2. Encapsulation Efficiency
3.4.3. Particles size and Surface Charge
3.4.4. Fourier Transform Infrared Spectroscopy
3.4.5. Scanning Electron Transmission Microscopy (STEM)
3.4.6. Functionalization of Fabrics with Keratin-Based Particles
3.5. Characterization of Functionalized Fabrics
3.5.1. Scanning Electron Microscope
3.5.2. Air Permeability
3.5.3. Thermogravimetric Analysis
3.5.4. Release of Terbinafine from Functionalized Textiles
3.6. Antimicrobial and Antifungal Activity
3.7. Statistical Analysis
4. Conclusions
Supplementary Materials
Author Contributions
Funding
Institutional Review Board Statement
Informed Consent Statement
Data Availability Statement
Conflicts of Interest
References
- Lipner, S.R.; Scher, R.K. Onychomycosis. J. Am. Acad. Dermatol. 2019, 80, 853–867. [Google Scholar] [CrossRef] [PubMed]
- Hawks, M.K.; Rupert, J.P.; Svarverud, J.E. Terbinafine for Onychomycosis. Am. Fam. Physician 2018, 98, Online, PMID: 30215902. [Google Scholar] [PubMed]
- Gupta, A.K.; Stec, N.; Summerbell, R.C.; Shear, N.H.; Piguet, V.; Tosti, A.; Piraccini, B.M. Onychomycosis: A Review. J. Eur. Acad. Dermatol. Venereol. 2020, 34, 1972–1990. [Google Scholar] [CrossRef] [PubMed]
- Zhang, M.; Jiang, L.; Li, F.; Xu, Y.; Lv, S.; Wang, B. Simultaneous Dermatophytosis and Keratomycosis Caused by Trichophyton Interdigitale Infection: A Case Report and Literature Review. BMC Infect. Dis. 2019, 19, 983. [Google Scholar] [CrossRef] [PubMed]
- Gupta, A.K.; Venkataraman, M.; Talukder, M. Onychomycosis in Older Adults: Prevalence, Diagnosis, and Management. Drugs Aging 2022, 39, 191–198. [Google Scholar] [CrossRef] [PubMed]
- Bodman, M.A.; Krishnamurthy, K. Onychomycosis. In StatPearls [Internet]; StatPearls Publishing: Treasure Island, FL, USA, 2022. [Google Scholar]
- Gupta, A.K.; Nakrieko, K.-A. Trichophyton Rubrum DNA Strains in Patients with Onychomycosis with Persistent Mixed Infections Involving a Nondermatophyte Mold. J. Am. Podiatr. Med. Assoc. 2020, 110, 3. [Google Scholar] [CrossRef]
- Ciesielska, A.; Kawa, A.; Kanarek, K.; Soboń, A.; Szewczyk, R. Metabolomic Analysis of Trichophyton Rubrum and Microsporum Canis during Keratin Degradation. Sci. Rep. 2021, 11, 3959. [Google Scholar] [CrossRef]
- Cornet, L.; D’hooge, E.; Magain, N.; Stubbe, D.; Packeu, A.; Baurain, D.; Becker, P. The Taxonomy of the Trichophyton Rubrum Complex: A Phylogenomic Approach. Microb. Genom. 2021, 7, 000707. [Google Scholar] [CrossRef]
- Westerberg, D.P.; Voyack, M.J. Onychomycosis: Current Trends in Diagnosis and Treatment. Am. Fam. Physician 2013, 88, 762–770. [Google Scholar]
- Leung, A.K.C.; Lam, J.M.; Leong, K.F.; Hon, K.L.; Barankin, B.; Leung, A.A.M.; Wong, A.H.C. Onychomycosis: An Updated Review. Recent Pat. Inflamm. Allergy Drug Discov. 2020, 14, 32–45. [Google Scholar] [CrossRef]
- Aggarwal, R.; Targhotra, M.; Kumar, B.; Sahoo, P.K.; Chauhan, M.K. Treatment and Management Strategies of Onychomycosis. J. Mycol. Med. 2020, 30, 100949. [Google Scholar] [CrossRef] [PubMed]
- Rajendra, V.; Baro, A.; Kumari, A.; Dhamecha, D.L.; Lahoti, S.; Shelke, S. Transungual Drug Delivery: An Overview. J. Appl. Pharm. Sci. 2012, 2, 203–209. [Google Scholar]
- Thatai, P.; Sapra, B. Transungual Delivery: Deliberations and Creeds. Int. J. Cosmet. Sci. 2014, 36, 398–411. [Google Scholar] [CrossRef]
- Ryder, N.S. Terbinafine: Mode of Action and Properties of the Squalene Epoxidase Inhibition. Br. J. Dermatol. 1992, 126, 2–7. [Google Scholar] [CrossRef] [PubMed]
- Maxfield, L.; Preuss, C.V.; Bermudez, R. Terbinafine. In StatPearls [Internet]; StatPearls Publishing: Treasure Island, FL, USA, 2022. [Google Scholar]
- Kreijkamp-Kaspers, S.; Hawke, K.; Guo, L.; Kerin, G.; Bell-Syer, S.E.; Magin, P.; Bell-Syer, S.V.; van Driel, M.L. Oral Antifungal Medication for Toenail Onychomycosis. Cochrane Database Syst. Rev. 2017, 7, CD010031. [Google Scholar] [CrossRef] [PubMed]
- Shavandi, A.; Silva, T.H.; Bekhit, A.A.; Bekhit, A.E.-D.A. Keratin: Dissolution, Extraction and Biomedical Application. Biomater. Sci. 2017, 5, 1699–1735. [Google Scholar] [CrossRef]
- Tinoco, A.; Gonçalves, J.; Silva, C.; Loureiro, A.; Gomes, A.C.; Cavaco-Paulo, A.; Ribeiro, A. Keratin-Based Particles for Protection and Restoration of Hair Properties. Int. J. Cosmet. Sci. 2018, 40, 408–419. [Google Scholar] [CrossRef]
- Mori, H.; Hara, M. Transparent Biocompatible Wool Keratin Film Prepared by Mechanical Compression of Porous Keratin Hydrogel. Mater. Sci. Eng. C Mater. Biol. Appl. 2018, 91, 19–25. [Google Scholar] [CrossRef]
- Morales, J.O.; McConville, J.T. Manufacture and Characterization of Mucoadhesive Buccal Films. Eur. J. Pharm. Biopharm. 2011, 77, 187–199. [Google Scholar] [CrossRef]
- Tinoco, A.; Rodrigues, R.M.; Machado, R.; Pereira, R.N.; Cavaco-Paulo, A.; Ribeiro, A. Ohmic Heating as an Innovative Approach for the Production of Keratin Films. Int. J. Biol. Macromol. 2020, 150, 671–680. [Google Scholar] [CrossRef]
- Tachibana, A.; Furuta, Y.; Takeshima, H.; Tanabe, T.; Yamauchi, K. Fabrication of Wool Keratin Sponge Scaffolds for Long-Term Cell Cultivation. J. Biotechnol. 2002, 93, 165–170. [Google Scholar] [CrossRef]
- Yao, C.-H.; Lee, C.-Y.; Huang, C.-H.; Chen, Y.-S.; Chen, K.-Y. Novel Bilayer Wound Dressing Based on Electrospun Gelatin/Keratin Nanofibrous Mats for Skin Wound Repair. Mater. Sci. Eng. C Mater. Biol. Appl. 2017, 79, 533–540. [Google Scholar] [CrossRef] [PubMed]
- Singaravelu, S.; Ramanathan, G.; Sivagnanam, U.T. Dual-Layered 3D Nanofibrous Matrix Incorporated with Dual Drugs and Their Synergetic Effect on Accelerating Wound Healing through Growth Factor Regulation. Mater. Sci. Eng. C Mater. Biol. Appl. 2017, 76, 37–49. [Google Scholar] [CrossRef] [PubMed]
- Aluigi, A.; Ballestri, M.; Guerrini, A.; Sotgiu, G.; Ferroni, C.; Corticelli, F.; Gariboldi, M.B.; Monti, E.; Varchi, G. Organic Solvent-Free Preparation of Keratin Nanoparticles as Doxorubicin Carriers for Antitumour Activity. Mater. Sci. Eng. C Mater. Biol. Appl. 2018, 90, 476–484. [Google Scholar] [CrossRef]
- Li, Y.; Lin, J.; Zhi, X.; Li, P.; Jiang, X.; Yuan, J. Triple Stimuli-Responsive Keratin Nanoparticles as Carriers for Drug and Potential Nitric Oxide Release. Mater. Sci. Eng. C Mater. Biol. Appl. 2018, 91, 606–614. [Google Scholar] [CrossRef]
- Curcio, M.; Blanco-Fernandez, B.; Diaz-Gomez, L.; Concheiro, A.; Alvarez-Lorenzo, C. Hydrophobically Modified Keratin Vesicles for GSH-Responsive Intracellular Drug Release. Bioconjug. Chem. 2015, 26, 1900–1907. [Google Scholar] [CrossRef] [PubMed]
- Sun, Z.; Yi, Z.; Cui, X.; Chen, X.; Su, W.; Ren, X.; Li, X. Tumor-Targeted and Nitric Oxide-Generated Nanogels of Keratin and Hyaluronan for Enhanced Cancer Therapy. Nanoscale 2018, 10, 12109–12122. [Google Scholar] [CrossRef]
- Sun, Z.; Yi, Z.; Zhang, H.; Ma, X.; Su, W.; Sun, X.; Li, X. Bio-Responsive Alginate-Keratin Composite Nanogels with Enhanced Drug Loading Efficiency for Cancer Therapy. Carbohydr. Polym. 2017, 175, 159–169. [Google Scholar] [CrossRef]
- Posati, T.; Giuri, D.; Nocchetti, M.; Sagnella, A.; Gariboldi, M.; Ferroni, C.; Sotgiu, G.; Varchi, G.; Zamboni, R.; Aluigi, A. Keratin-Hydrotalcites Hybrid Films for Drug Delivery Applications. Eur. Polym. J. 2018, 105, 177–185. [Google Scholar] [CrossRef]
- Alahyaribeik, S.; Ullah, A. Methods of Keratin Extraction from Poultry Feathers and Their Effects on Antioxidant Activity of Extracted Keratin. Int. J. Biol. Macromol. 2020, 148, 449–456. [Google Scholar] [CrossRef]
- Elzoghby, A.O.; Samy, W.M.; Elgindy, N.A. Protein-Based Nanocarriers as Promising Drug and Gene Delivery Systems. J. Control. Release 2012, 161, 38–49. [Google Scholar] [CrossRef] [PubMed]
- Liu, P.; Wu, Q.; Li, Y.; Li, P.; Yuan, J.; Meng, X.; Xiao, Y. DOX-Conjugated Keratin Nanoparticles for PH-Sensitive Drug Delivery. Colloids Surf. B Biointerfaces 2019, 181, 1012–1018. [Google Scholar] [CrossRef] [PubMed]
- Suk, J.S.; Xu, Q.; Kim, N.; Hanes, J.; Ensign, L.M. PEGylation as a Strategy for Improving Nanoparticle-Based Drug and Gene Delivery. Adv. Drug Deliv. Rev. 2016, 99, 28–51. [Google Scholar] [CrossRef] [PubMed]
- Shi, L.; Zhang, J.; Zhao, M.; Tang, S.; Cheng, X.; Zhang, W.; Li, W.; Liu, X.; Peng, H.; Wang, Q. Effects of Polyethylene Glycol on the Surface of Nanoparticles for Targeted Drug Delivery. Nanoscale 2021, 13, 10748–10764. [Google Scholar] [CrossRef] [PubMed]
- Mayolo-Deloisa, K.; González-González, M.; Simental-Martínez, J.; Rito-Palomares, M. Aldehyde PEGylation of Laccase from Trametes Versicolor in Route to Increase Its Stability: Effect on Enzymatic Activity. J. Mol. Recognit. 2015, 28, 173–179. [Google Scholar] [CrossRef] [PubMed]
- Angamuthu, M.; Nanjappa, S.H.; Raman, V.; Jo, S.; Cegu, P.; Narasimha Murthy, S. Controlled-Release Injectable Containing Terbinafine/PLGA Microspheres for Onychomycosis Treatment. J. Pharm. Sci. 2014, 103, 1178–1183. [Google Scholar] [CrossRef]
- Tinoco, A.; Gonçalves, F.; Costa, A.F.; Freitas, D.S.; Cavaco-Paulo, A.; Ribeiro, A. Keratin:Zein Particles as Vehicles for Fragrance Release on Hair. Ind. Crops Prod. 2021, 159, 113067. [Google Scholar] [CrossRef]
- Jain, A.; Singh, S.K.; Arya, S.K.; Kundu, S.C.; Kapoor, S. Protein Nanoparticles: Promising Platforms for Drug Delivery Applications. ACS Biomater. Sci. Eng. 2018, 4, 3939–3961. [Google Scholar] [CrossRef]
- Savian, A.L.; Rodrigues, D.; Weber, J.; Ribeiro, R.F.; Motta, M.H.; Schaffazick, S.R.; Adams, A.I.H.; de Andrade, D.F.; Beck, R.C.R.; da Silva, C.B. Dithranol-Loaded Lipid-Core Nanocapsules Improve the Photostability and Reduce the in Vitro Irritation Potential of This Drug. Mater. Sci. Eng. C 2015, 46, 69–76. [Google Scholar] [CrossRef]
- Tan, Q.; Liu, W.; Guo, C.; Zhai, G. Preparation and Evaluation of Quercetin-Loaded Lecithin-Chitosan Nanoparticles for Topical Delivery. Int. J. Nanomed. 2011, 6, 1621–1630. [Google Scholar] [CrossRef]
- Cheng, Z.; Chen, X.; Zhai, D.; Gao, F.; Guo, T.; Li, W.; Hao, S.; Ji, J.; Wang, B. Development of Keratin Nanoparticles for Controlled Gastric Mucoadhesion and Drug Release. J. Nanobiotech. 2018, 16, 24. [Google Scholar] [CrossRef] [PubMed]
- Gonçalves, J.; Torres, N.; Silva, S.; Gonçalves, F.; Noro, J.; Cavaco-Paulo, A.; Ribeiro, A.; Silva, C. Zein Impart Hydrophobic and Antimicrobial Properties to Cotton Textiles. React. Funct. Polym. 2020, 154, 104664. [Google Scholar] [CrossRef]
- Rani, S.; Sharma, A.K.; Khan, I.; Gothwal, A.; Chaudhary, S.; Gupta, U. Polymeric Nanoparticles in Targeting and Delivery of Drugs. In Nanotechnology-Based Approaches for Targeting and Delivery of Drugs and Genes; Elsevier: Amsterdam, The Netherlands, 2017; pp. 223–255. [Google Scholar]
- Iizhar, S.A.; Syed, I.A.; Satar, R.; Ansari, S.A. In Vitro Assessment of Pharmaceutical Potential of Ethosomes Entrapped with Terbinafine Hydrochloride. J. Adv. Res. 2016, 7, 453–461. [Google Scholar] [CrossRef] [PubMed]
- Abril, D.; Mirabal-Gallardo, Y.; González, A.; Marican, A.; Durán-Lara, E.F.; Silva Santos, L.; Valdés, O. Comparison of the Oxidative Stability and Antioxidant Activity of Extra-Virgin Olive Oil and Oils Extracted from Seeds of Colliguaya Integerrima and Cynara Cardunculus Under Normal Conditions and After Thermal Treatment. Antioxidants 2019, 8, 470. [Google Scholar] [CrossRef] [PubMed]
- Costa, T.; Ribeiro, A.; Machado, R.; Ribeiro, C.; Lanceros-Mendez, S.; Cavaco-Paulo, A.; Almeida, A.; das Neves, J.; Lúcio, M.; Viseu, T. Polymeric Electrospun Fibrous Dressings for Topical Co-Delivery of Acyclovir and Omega-3 Fatty Acids. Front. Bioeng. Biotechnol. 2019, 7, 390. [Google Scholar] [CrossRef]
- Martiska, J.; Snejdrova, E.; Drastik, M.; Matysova, L.; Dittrich, M.; Loskot, J.; Jilek, P. Terbinafine-Loaded Branched PLGA-Based Cationic Nanoparticles with Modifiable Properties. Pharm. Dev. Technol. 2019, 24, 1308–1316. [Google Scholar] [CrossRef]
- Elmataeeshy, M.E.; Sokar, M.S.; Bahey-El-Din, M.; Shaker, D.S. Enhanced Transdermal Permeability of Terbinafine through Novel Nanoemulgel Formulation; Development, In Vitro and In Vivo Characterization. Futur. J. Pharm. Sci. 2018, 4, 18–28. [Google Scholar] [CrossRef]
- Şen, M.; Yakar, A. Controlled Release of Antifungal Drug Terbinafine Hydrochloride from Poly(N-Vinyl 2-Pyrrolidone/Itaconic Acid) Hydrogels. Int. J. Pharm. 2001, 228, 33–41. [Google Scholar] [CrossRef]
- Mishra, R.; Militky, J.; Venkataraman, M. Nanoporous Materials. In Nanotechnology in Textiles; Elsevier: Amsterdam, The Netherlands, 2019; pp. 311–353. [Google Scholar]
- Adamu, B.F.; Gao, J. Comfort Related Woven Fabric Transmission Properties Made of Cotton and Nylon. Fash. Text. 2022, 9, 8. [Google Scholar] [CrossRef]
- Noman, M.T.; Petru, M.; Amor, N.; Louda, P. Thermophysiological Comfort of Zinc Oxide Nanoparticles Coated Woven Fabrics. Sci. Rep. 2020, 10, 21080. [Google Scholar] [CrossRef]
- Saleemi, S.; Naveed, T.; Riaz, T.; Memon, H.; Awan, J.A.; Siyal, M.I.; Xu, F.; Bae, J. Surface Functionalization of Cotton and PC Fabrics Using SiO2 and ZnO Nanoparticles for Durable Flame Retardant Properties. Coatings 2020, 10, 124. [Google Scholar] [CrossRef]
- Ayutthaya, S.I.N.; Tanpichai, S.; Wootthikanokkhan, J. Keratin Extracted from Chicken Feather Waste: Extraction, Preparation, and Structural Characterization of the Keratin and Keratin/Biopolymer Films and Electrospuns. J. Polym. Environ. 2015, 23, 506–516. [Google Scholar] [CrossRef]
- Tinoco, A.; Costa, A.F.; Luís, S.; Martins, M.; Cavaco-Paulo, A.; Ribeiro, A. Proteins as Hair Styling Agents. Appl. Sci. 2021, 11, 4245. [Google Scholar] [CrossRef]
- Rodrigues, R.M.; Pereira, R.N.; Vicente, A.A.; Cavaco-Paulo, A.; Ribeiro, A. Ohmic Heating as a New Tool for Protein Scaffold Engineering. Mater. Sci. Eng. C 2021, 120, 111784. [Google Scholar] [CrossRef] [PubMed]

| Particles | Formation Efficiency (%) | Encapsulation Efficiency (%) |
|---|---|---|
| 100% keratin | 90.70 ± 0.60 | -------- |
| 100% keratin-Terb | 90.10 ± 0.10 | 99.8 ± 0.10 |
| 80% keratin/20% keratin-PEG | 92.30 ± 0.20 | -------- |
| 80% keratin/20% keratin-PEG-Terb | 93.50 ± 0.40 | 99.9 ± 0.50 |
| Fabric | Weight Gain (%) (±SD) |
|---|---|
| 100% keratin | 5.07 ± 0.03 |
| 100% keratin-Terb | 5.03 ± 0.07 |
| 80% keratin/20% keratin-PEG | 4.31 ± 0.23 |
| 80% keratin/20% keratin-PEG-Terb | 5.59 ± 0.05 |
Publisher’s Note: MDPI stays neutral with regard to jurisdictional claims in published maps and institutional affiliations. |
© 2022 by the authors. Licensee MDPI, Basel, Switzerland. This article is an open access article distributed under the terms and conditions of the Creative Commons Attribution (CC BY) license (https://creativecommons.org/licenses/by/4.0/).
Share and Cite
Costa, A.F.; Luís, S.; Noro, J.; Silva, S.; Silva, C.; Ribeiro, A. Therapeutic Textiles Functionalized with Keratin-Based Particles Encapsulating Terbinafine for the Treatment of Onychomycosis. Int. J. Mol. Sci. 2022, 23, 13999. https://doi.org/10.3390/ijms232213999
Costa AF, Luís S, Noro J, Silva S, Silva C, Ribeiro A. Therapeutic Textiles Functionalized with Keratin-Based Particles Encapsulating Terbinafine for the Treatment of Onychomycosis. International Journal of Molecular Sciences. 2022; 23(22):13999. https://doi.org/10.3390/ijms232213999
Chicago/Turabian StyleCosta, André F., Salomé Luís, Jennifer Noro, Sónia Silva, Carla Silva, and Artur Ribeiro. 2022. "Therapeutic Textiles Functionalized with Keratin-Based Particles Encapsulating Terbinafine for the Treatment of Onychomycosis" International Journal of Molecular Sciences 23, no. 22: 13999. https://doi.org/10.3390/ijms232213999
APA StyleCosta, A. F., Luís, S., Noro, J., Silva, S., Silva, C., & Ribeiro, A. (2022). Therapeutic Textiles Functionalized with Keratin-Based Particles Encapsulating Terbinafine for the Treatment of Onychomycosis. International Journal of Molecular Sciences, 23(22), 13999. https://doi.org/10.3390/ijms232213999

